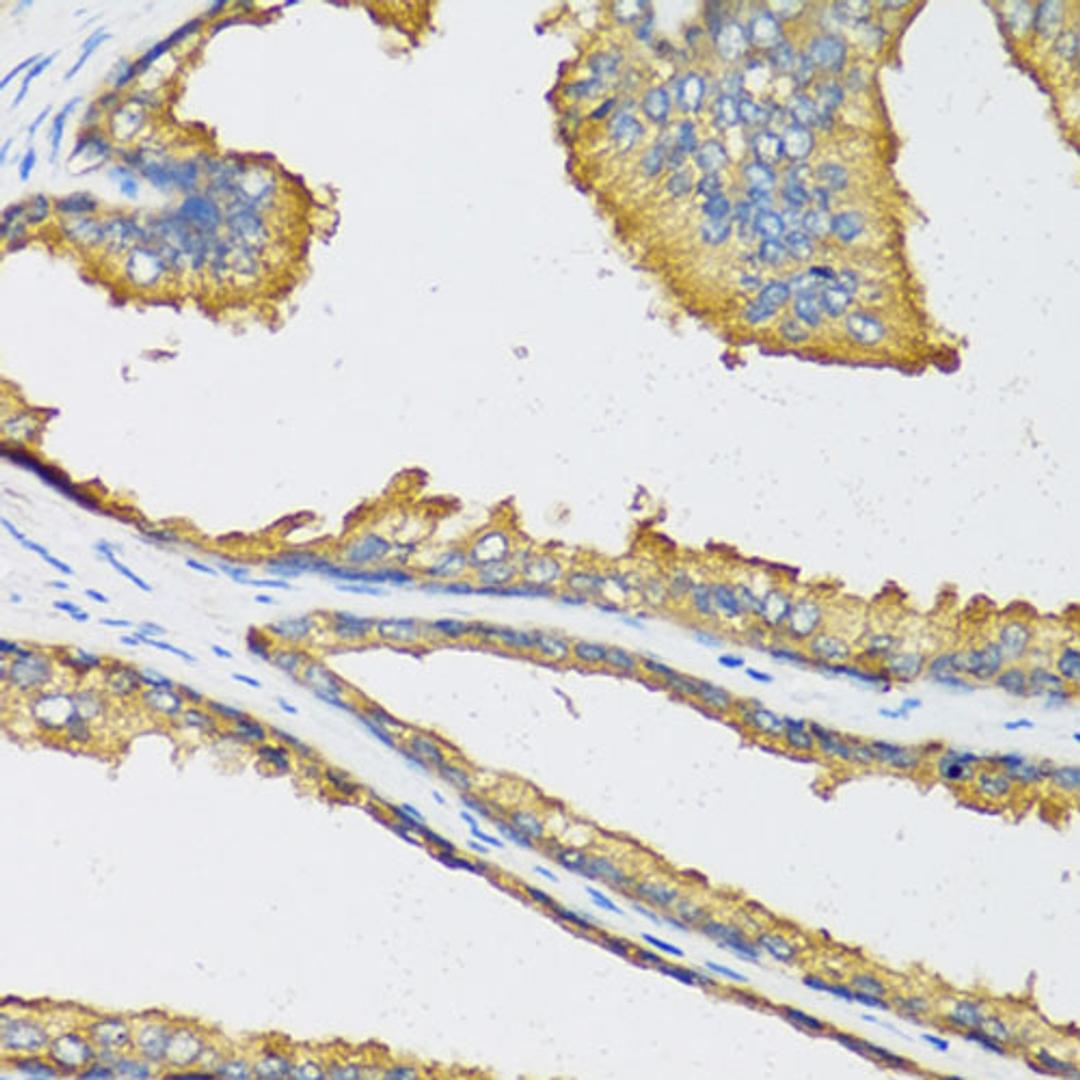
Immunohistochemistry - CXCL11 antibody (A6201)

CXCL11 Rabbit pAb
Product Details
- Cat. No.
- A6201
- Type
- Primary Antibody
- Clonality
- Polyclonal
- Host
- Rabbit

The supplier does not provide quotations for this antibody through SelectScience. You can search for similar antibodies in our Antibody Directory.
Description
Chemokines are a group of small (approximately 8 to 14 kD), mostly basic, structurally related molecules that regulate cell trafficking of various types of leukocytes through interactions with a subset of 7-transmembrane, G protein-coupled receptors. Chemokines also play fundamental roles in the development, homeostasis, and function of the immune system, and they have effects on cells of the central nervous system as well as on endothelial cells involved in angiogenesis or angiostasis. Chemokines are divided into 2 major subfamilies, CXC and CC. This antimicrobial gene is a CXC member of the chemokine superfamily. Its encoded protein induces a chemotactic response in activated T-cells and is the dominant ligand for CXC receptor-3. The gene encoding this protein contains 4 exons and at least three polyadenylation signals which might reflect cell-specific regulation of expression. IFN-gamma is a potent inducer of transcription of this gene. Two transcript variants encoding different isoforms have been found for this gene.
Biological Information
- Clonality: Polyclonal
- Host: Rabbit
- Reactivity: Human